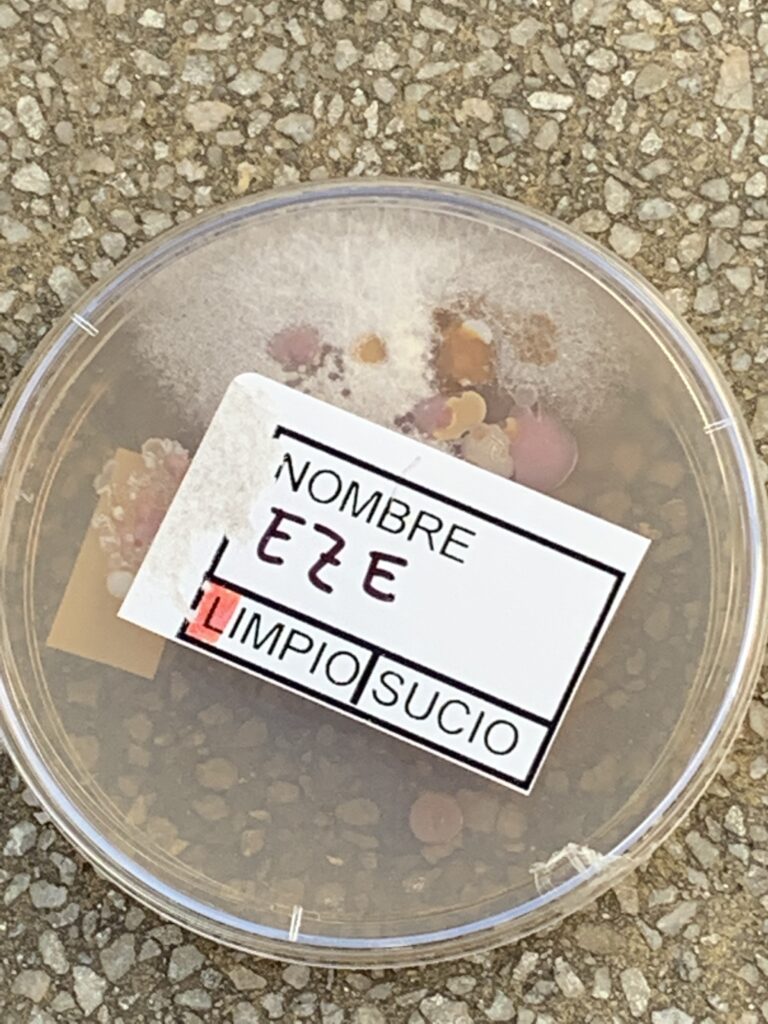

El cuidado de la salud inicia desde edades tempranas con la correcta higiene de manos para prevenir enfermedades… Por eso es tan importante el lavado después de ir al baño, cuando llegamos a nuestras casas y cuando vamos a comer.
Para visualizar los microorganismos que se encuentran en las manos sucias, les propusimos a los alumnos y alumnas de 1er grado la siguiente experiencia:
Para comenzar se dividieron en dos grupos:
- Grupo 1: No se lava las manos.
- Grupo 2: Se lava las manos con jabón.



Utilizamos recipientes individuales para cada niño/a llamados “Placa de Petri” conteniendo dentro de él, una especie de gelatina, medio que ayuda a los microorganismos a crecer rápidamente y de esta forma, poder visualizarlos.








Cada niño/a eligió una de sus manos y la apoyó suavemente en la gelatina durante 5 segundos. Los recipientes rotulados fueron llevados a una estufa que tiene una temperatura especial para favorecer la propagación de los microorganismos.
Al cabo de unos días, nos pusimos los guantes y observamos qué pasó con nuestras Plaquitas de Petri….








Observamos que los microorganismos había crecido tanto como para verlos a simple vista!!! Y para nuestra sorpresa… estaban en las placas de ambos grupos… el de las manos “limpias” y el de las manos sucias!
Esta experiencia nos llevó a pensar en la importancia del lavado correcto de manos en la prevención de las enfermedades…
Aquí van algunos consejos útiles….


